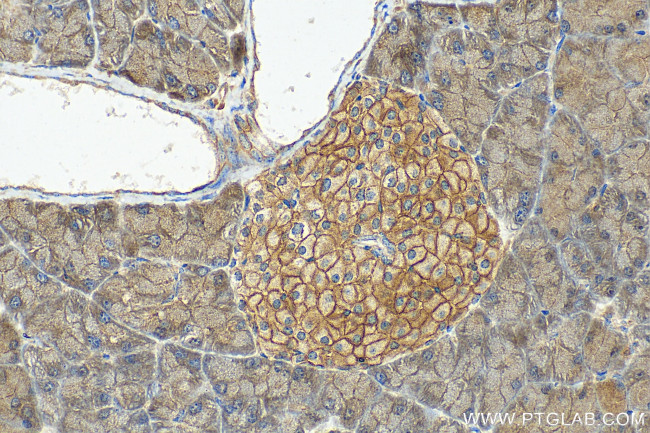
TMEM66 Antibody in Immunohistochemistry (Paraffin) (IHC (P))

Search
Proteintech
TMEM66 Polyclonal Antibody
{{$productOrderCtrl.translations['antibody.pdp.commerceCard.promotion.promotions']}}
{{$productOrderCtrl.translations['antibody.pdp.commerceCard.promotion.viewpromo']}}
{{$productOrderCtrl.translations['antibody.pdp.commerceCard.promotion.promocode']}}: {{promo.promoCode}} {{promo.promoTitle}} {{promo.promoDescription}}. {{$productOrderCtrl.translations['antibody.pdp.commerceCard.promotion.learnmore']}}
产品信息
29599-1-AP
种属反应
宿主/亚型
分类
类型
抗原
偶联物
形式
浓度
规格
纯化类型
保存液
内含物
保存条件
运输条件
产品详细信息
Immunogen sequence: NDPDRMLLRD VKALTLHYDR YTTSRRLDPI PQLKCVGGTA GCDSYTPKVI QCQNKGWDGY DVQWECKTDL DIAYKFGKTV VSCEGYESSE DQYVLRGSCG LEYNLDYTEL GLQKLKESGK QHGFASFSDY YYKWSSADSC NMSGLITIVV LL
靶标信息
Saraf encodes a protein that is a negative regulator of store-operated Ca(2+) entry (SOCE) involved in protecting cells from Ca(2+) overfilling. In response to cytosolic Ca(2+) elevation after endoplasmic reticulum Ca(2+) refilling, promotes a slow inactivation of STIM (STIM1 or STIM2)-dependent SOCE activity: possibly act by facilitating the de-oligomerization of STIM to efficiently turn off ORAI when the endoplasmic reticulum lumen is filled with the appropriate Ca(2+) levels, and thus preventing the overload of the cell with excessive Ca(2+) ions.
仅用于科研。不用于诊断过程。未经明确授权不得转售。
篇参考文献 (0)
生物信息学
蛋白别名: HBV X-transactivated gene 3 protein; HBV XAg-transactivated protein 3; protein 3 transactivated by hepatitis B virus X antigen (HBxAg); Protein FOAP-7; SARAF; SOCE-associated regulatory factor; Store-operated calcium entry-associated regulatory factor; testicular secretory protein Li 59; Transmembrane protein 66; unnamed protein product
基因别名: 1810045K07Rik; FOAP-7; HSPC035; NPD003; PSEC0019; SARAF; TMEM66; UNQ1967/PRO4499; XTP3
UniProt ID: (Human) Q96BY9, (Mouse) Q8R3Q0
Entrez Gene ID: (Human) 51669, (Mouse) 67887